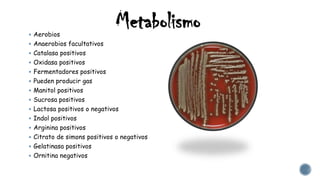
Metabolismo Aerobios
 Anaerobios facultativos
 Catalasa positivos
 Oxidasa positivos
 Fermentadores positivos
 Pueden producir gas
 Manitol positivos
 Sucrosa positivos
 Lactosa positivos o negativos
 Indol positivos
 Arginina positivos
 Citrato de simons positivos o negativos
 Gelatinasa positivos
 Ornitina negativos

Este documento describe tres géneros de bacterias de importancia médica: Vibrio, Aeromonas y Plesiomonas. Se detalla que Vibrio cholerae, V. parahaemolyticus y V. vulnificus son las especies de Vibrio más importantes, causando enfermedades como el cólera. También se explican las características, factores de virulencia, manifestaciones clínicas, diagnóstico y tratamiento de estas bacterias.